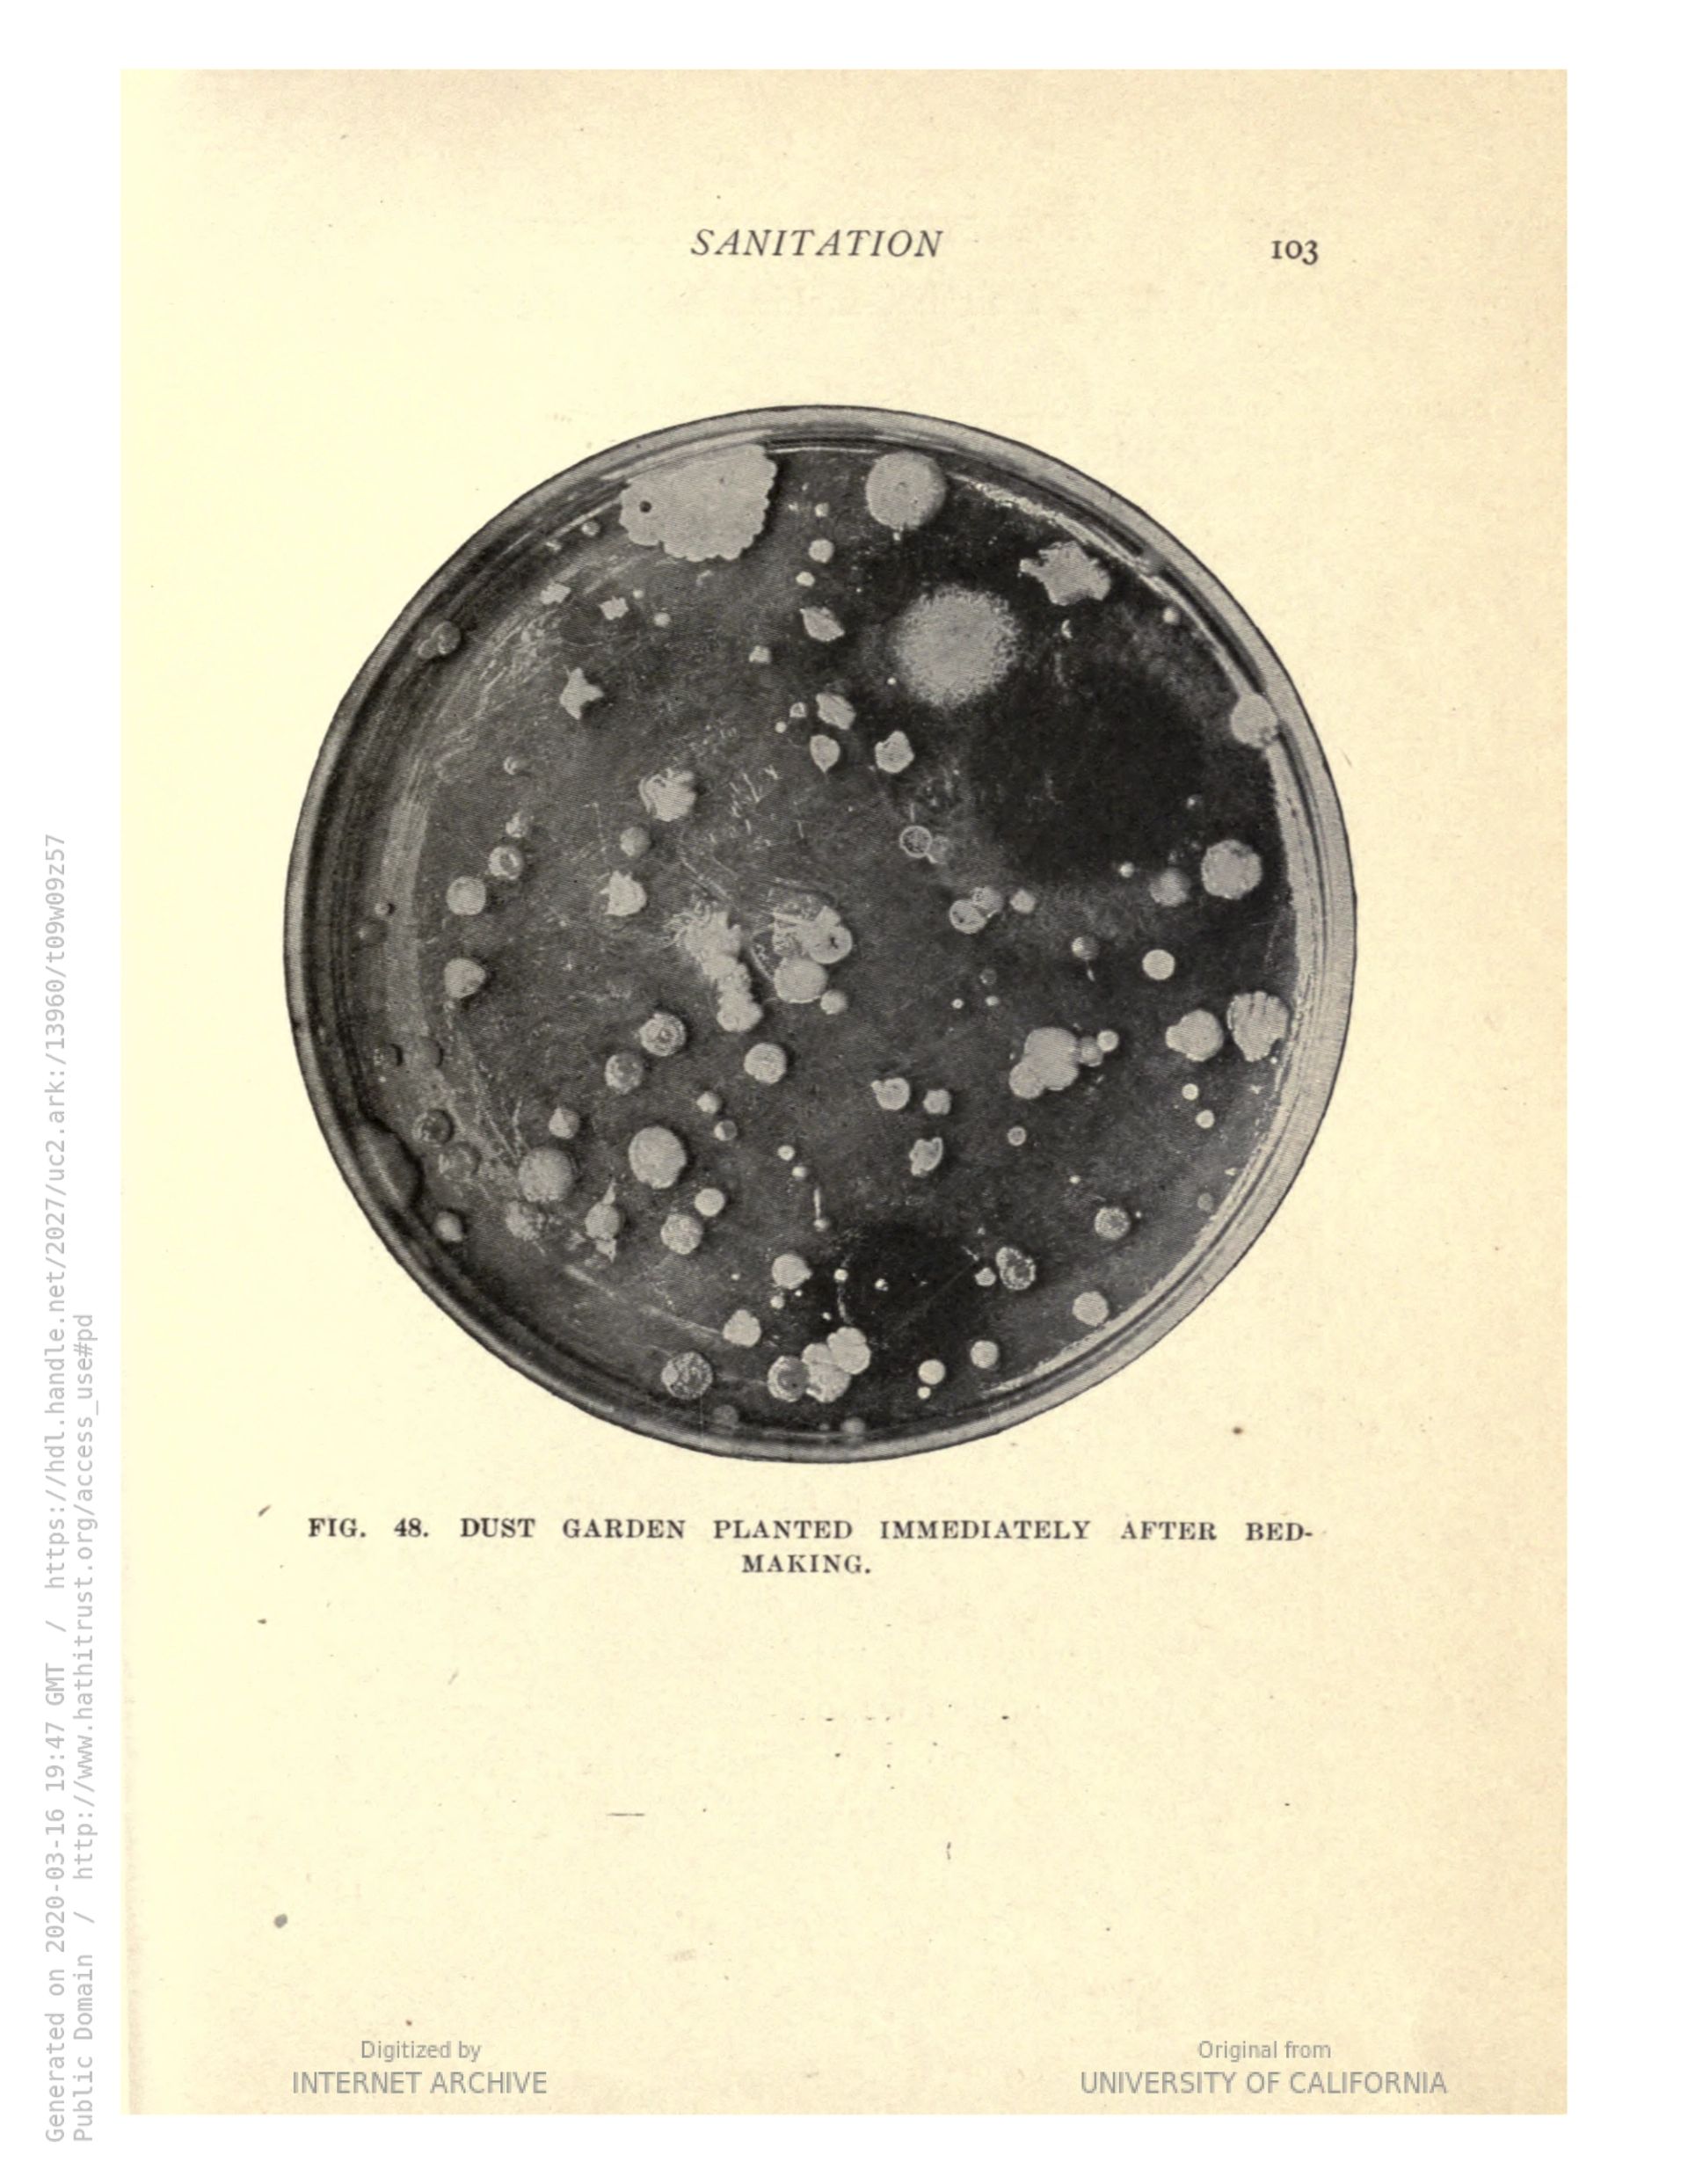

Prada Frames: Being Home examines the living environment as a framework to address contemporary challenges. The home is not merely a source of comfort; it is a shelter and an infrastructure of services. This constantly evolving space is also where socio-economic norms have historically been shaped. The symposium explores domestic infrastructures, housing precarity, socio-economic structures and systems of governance, the impact of technological advancements on sleep, leisure, and labour, societal biases, and alternative forms of togetherness and intimacy.
Listen to all episodes on Spotify and Apple Podcasts.
The session analyses Earth as our shared living room, investigating its diverse co-inhabiting forms, such as the Amazon forest, Modernist architectures and socially unequal cityscapes.
The session explores the living room as a receptacle of collective practices, historical and colonial legacies, geopolitical forces, and societal biases, with the aim of cultivating new perspectives on homemaking.
The session examines how design has evolved to address various behaviors, needs, and ways of living. It will then explore cell phones as contemporary living spaces and investigates architectures that foster shared intimacy.
The session explores the relationships between the scales of the room, the house, and the street, inspired by Virginia Woolf’s concept of ‘a room of one’s own’. The session then examines the influence of generative technological advancements on these scales.
The session looks into everyday practices and domestic infrastructures through economic histories and narratives. The session also explores practices of care and collective ownership beyond traditional monolithic definitions of the home.
References
London Renters Union, accompanying Alva Gotby's presentation.
The LIVING ROOM SESSIONS explore domestic infrastructures through their socio-economic histories, collective ownership configurations, and the impact of technological advancements and societal biases on living rooms. These sessions aim to cultivate new perspectives on homemaking and explore alternative cohabitation models.
The session explores architectures as performances and rituals of community care and gathering.
The session looks into the domesticity of kitchens as spaces of reconfigured relationships and daily micro-politics.
The session examines how the kitchen shapes socio-economic norms and gender biases. It also investigates collective community kitchen practices as acts of political resistance.
The DINING ROOM SESSIONS explore the communal nature of this space, examining how kitchens have shaped socio-economic norms and gender biases. The sessions look into domesticity and forms of gatherings as political resistance.
The session looks into the multiscalar dimensions of a bathroom, exploring the systems and technologies that shape the space.
The session investigates the bathroom as an immersive body of water and an architecture of streams, fluids, sex, and gender.
References
"A Bigger Splash", David Hockney, 1963. [online]
The session explores the bathroom as a space for healing, toxicity, and hidden infrastructures and will then look into feminist politics of leisure and the struggles to recognize, redistribute, and reduce domestic labour.
References
King’s Scholars’ Pond Sewer, London. Courtesy of Adam Powell. Image 5 accompanying Marina Otero Verzier's presentation. [online]
The BATHROOM SESSIONS look into the fluidity of this space, exploring feminist politics of leisure and labour, gender roles, hidden infrastructures shaping its dynamics and new forms of healing and togetherness.
The session explores living beyond the perimeter of the home, examining human productive practices in the garden and the reproductive rituals of animals.
Please note that this episode is in Italian, an edited English translation is available below.
The session explores living beyond the perimeter of the home, from narratives of gardening, farming and the reproductive rituals of animals, through global histories of cultivation and domestication.
References
Picciola, 1853, Robert Braithwaite Martineau. Image accompanying Mary Kuhn's presentation. [online]
The session analyses the interplay between the technical and the emotional realities within a home, examining how materials, real estate codes, regulations and feelings shape the essence of the modern home.
The LIBRARY SESSIONS examine relationships and perspectives outside the confines of a home. The library at Milan’s Museo Bagatti Valsecchi, characterised by wooden panels and an extensive collection of books and encyclopaedias, provides its users with access to both a garden of timber species and a garden of knowledge.
The session considers the bedroom as a space shaped by emerging sleep norms in 19th-century Europe and North America, and how these norms, in turn, have influenced socio-economic structures in societies.
The session delves into the bedroom's role as a comfort zone, examining how heat, air, and humidity serve as architectural materials, while addressing tensions between the private and public spheres.
The BEDROOM SESSIONS explore sleep as a socio-economic construct, navigating the tensions between the private and public spheres and the material and immaterial properties of the room.
Milan’s Museo Bagatti Valsecchi — once a fantastical house erected by two rather eccentric brothers — plays host to Prada Frames: Being Home, gathering intimate conversations and thematic lectures which occur simultaneously in various rooms: bedroom, library, bathroom, dining room and the living room — all of which you can find as podcast episodes via this site, on Spotify and Apple Podcasts. You will also hear from host, design critic and writer Alice Rawsthorn, elaborating each of these room typologies, connecting their evolutions to broader shifts in social, political, and cultural landscapes. For this first and very special episode, we’re sitting with the brains behind the brilliance, before it all begins; namely: Prada Frames curators Simone Farresin and Andrea Trimarchi of FormaFantasma, and hosts Alice Rawsthorn and Natalia Grabowska.
The session looks at living spaces as normative enclosures and holders of bodies that are yet to be dismantled, queering vessels hosting alternative family structures. The session also explores rituals of diaspora communities in architectural space and homemaking.